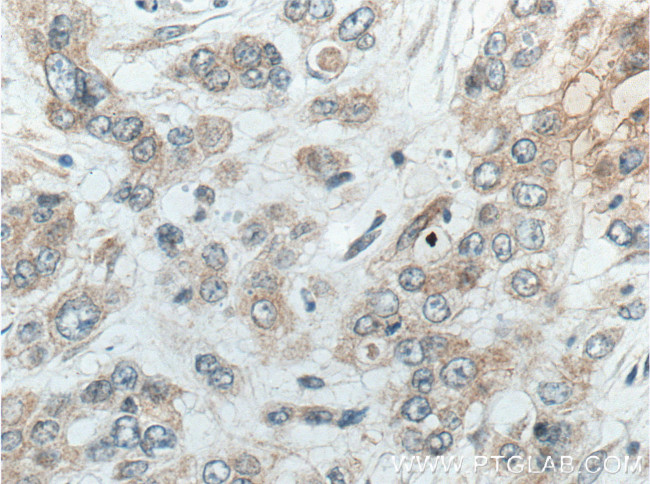
ACOT9 Antibody in Immunohistochemistry (Paraffin) (IHC (P))

Search
Proteintech
ACOT9 Monoclonal Antibody (3F10G5)
{{$productOrderCtrl.translations['antibody.pdp.commerceCard.promotion.promotions']}}
{{$productOrderCtrl.translations['antibody.pdp.commerceCard.promotion.viewpromo']}}
{{$productOrderCtrl.translations['antibody.pdp.commerceCard.promotion.promocode']}}: {{promo.promoCode}} {{promo.promoTitle}} {{promo.promoDescription}}. {{$productOrderCtrl.translations['antibody.pdp.commerceCard.promotion.learnmore']}}
产品信息
66532-1-IG
种属反应
宿主/亚型
分类
类型
克隆号
抗原
偶联物
形式
浓度
纯化类型
保存液
内含物
保存条件
运输条件
产品详细信息
Immunogen sequence: MRRAALRLC ALGKGQLTPG RGLTQGPQNP KKQGIFHIHE VRDKLREIVG ASTNWRDHVK AMEERKLLHS FLAKSQDGLP PRRMKDSYIE VLLPLGSEPE LREKYLTVQN TVRFGRILED LDSLGVLICY MHNKIHSAKM SPLSIVTALV DKIDMCKKSL SPEQDIKFSG HVSWVGKTSM EVKMQMFQLH GDEFCPVLDA TFVMVARDSE NKG (1-212 aa encoded by BC012573)
靶标信息
Acyl-CoA thioesterases (ACOTs) are a group of enzymes that catalyze the hydrolysis of acyl-CoA to form coenzyme A (CoA) and a free fatty acid. Through their catalytic activity, ACOTs are able to regulate the level of fatty acids and acyl-CoAs within the cell. ACOT9 (acyl-CoA thioesterase 9), also known as ACATE2, MT-ACT48 (mitochondrial acyl-CoA thioesterase of 48 kDa) or CGI-16, is a 406 amino acid member of the acyl-CoA hydrolase protein family. ACOT9 contains a C-terminal 80-amino acid domain that is conserved from mouse to human, suggesting that the C-terminus may confer the catalytic activity of ACOT9. The gene encoding ACOT9 is located on chromosome X and the expressed ACOT9 protein is localized to the mitochondrion.
仅用于科研。不用于诊断过程。未经明确授权不得转售。
篇参考文献 (0)
生物信息学
蛋白别名: Acyl coenzyme A thioester hydrolase 2; Acyl-CoA thioester hydrolase 9; Acyl-CoA thioesterase 9; acyl-Coenzyme A thioesterase 2, mitochondrial; Acyl-coenzyme A thioesterase 9, mitochondrial; Mitochondrial 48 kDa acyl-CoA thioester hydrolase 1; mitochondrial Acyl-CoA Thioesterase; Mt-ACT48.1; MTE-2; p48; Protein U8
基因别名: 0610041P13Rik; ACATE2; ACOT9; C76421; CGI-16; MT-ACT48; MTACT48; p48; U8
UniProt ID: (Human) Q9Y305, (Mouse) Q9R0X4
Entrez Gene ID: (Human) 23597, (Mouse) 56360, (Rat) 302640